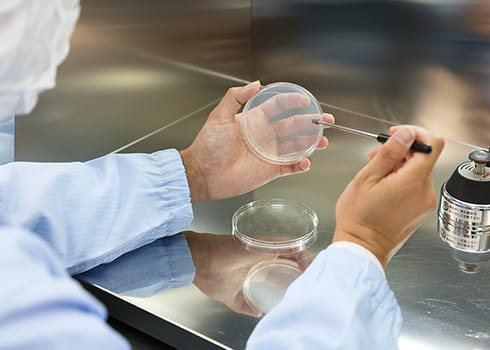

INITIATIVE当社の取り組み
当社の取り組み
-
品質
有資格者の指導による5Sの徹底、落下菌検査、クリーンルーム内の粉塵測定を定期的に実施することにより、お客様が安心して使用できる徹底した管理を行っております。
-

設備
当社のクリーンルームは、ISOクラス1の洗浄度で0.1㎛の粉塵が10個以下という最も洗浄度が高い半導体工場などでも使用されるクリーンルームを導入しております。
-

設備
主力製品の採便管の製造には、省人化、コンタミネーション防止、需要の増加を解決するために全自動分注機を計4台導入しております。
-

環境
ディスポーザブル容器の課題である医療廃棄物を考えた小型容器の開発、電力消費の少ないクリーンルーム、プラスチック汚染に関する該当物質の不使用などその他にも様々な取り組みをしております。
